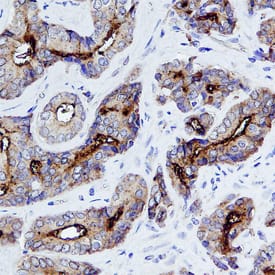
NAALADase I antibody in Human Prostate by Immunohistochemistry (IHC-P).

Human PSMA/FOLH1/NAALADase I Antibody
R&D Systems, part of Bio-Techne | Catalog # MAB4234


Key Product Details
Species Reactivity
Validated:
Cited:
Applications
Validated:
Cited:
Label
Antibody Source
Product Specifications
Immunogen
Lys44-Ala750
Accession # Q04609
Specificity
Clonality
Host
Isotype
Scientific Data Images for Human PSMA/FOLH1/NAALADase I Antibody
Detection of Human NAALADase I by Western Blot.
Western blot shows lysates of human prostate tissue. PVDF membrane was probed with 2 µg/mL of Mouse Anti-Human PSMA/FOLH1/NAALADase I Monoclonal Antibody (Catalog # MAB4234) followed by HRP-conjugated Anti-Mouse IgG Secondary Antibody (Catalog # HAF007). A specific band was detected for NAALADase I at approximately 120 kDa (as indicated). This experiment was conducted under reducing conditions and using Immunoblot Buffer Group 1.Detection of NAALADase I in LNCaP Human Cell Line by Flow Cytometry.
LNCaP human prostate cancer cell line was stained with Mouse Anti-Human PSMA/FOLH1/NAALADase I Monoclonal Antibody (Catalog # MAB4234, filled histogram) or isotype control antibody (Catalog # MAB003, open histogram), followed by Phycoerythrin-conjugated Anti-Mouse IgG Secondary Antibody (Catalog # F0102B).NAALADase I in PC‑3 Human Cell Line.
NAALADase I was detected in immersion fixed PC-3 human prostate cancer cell line using Mouse Anti-Human PSMA/FOLH1/ NAALADase I Monoclonal Antibody (Catalog # MAB4234) at 10 µg/mL for 3 hours at room temperature. Cells were stained using the NorthernLights™ 557-conjugated Anti-Mouse IgG Secondary Antibody (red; Catalog # NL007) and counterstained with DAPI (blue). Specific staining was localized to cell surfaces and cytoplasm. View our protocol for Fluorescent ICC Staining of Cells on Coverslips.Applications for Human PSMA/FOLH1/NAALADase I Antibody
CyTOF-ready
Flow Cytometry
Sample: LNCaP human prostate cancer cell line
Immunocytochemistry
Sample: Immersion fixed PC‑3 human prostate cancer cell line
Immunohistochemistry
Sample: Immersion fixed paraffin-embedded sections of human prostate
Western Blot
Sample: Human prostate tissue
Reviewed Applications
Read 2 reviews rated 5 using MAB4234 in the following applications:
Formulation, Preparation, and Storage
Purification
Reconstitution
Formulation
Shipping
Stability & Storage
- 12 months from date of receipt, -20 to -70 °C as supplied.
- 1 month, 2 to 8 °C under sterile conditions after reconstitution.
- 6 months, -20 to -70 °C under sterile conditions after reconstitution.
Background: PSMA/FOLH1/NAALADase I
Human prostate-specific membrane antigen (PSMA), a tumor marker in prostate cancer encoded by the FOLH1 gene, is a type II transmembrane zinc metallopeptidase that is most highly expressed in the nervous system, prostate, kidney, and small intestine (1, 2). The enzyme is also known as glutamate carboxypeptidase II (GCPII), folate hydrolase 1, folypoly-gamma-glutamate carboxypeptidase (FGCP), and N-acetylated-alpha-linked acidic dipeptidase I (NAALADase I). In the brain, PSMA hydrolyzes the neurotransmitter N-acetyl-Asp-Glu to produce glutamate, another neurotransmitter. Inhibition of brain PSMA activity is considered to be a promising approach for the treatment of neurological disorders associated with glutamate excitotoxicity, such as stroke, chronic pain, and amyotrophic lateral sclerosis (3). Intestinal PSMA hydrolyzes folylpoly-gamma -glutamates, facilitating the uptake of folate (4).
References
- Silver, D.A. et al. (1997) Clin. Cancer Res. 3:81.
- Carter, R.E. et al. (1996) Pro. Natl. Acad. Sci. USA. 93:749.
- Jackson, P.F. and Slusher, B.S. (2001) Curr. Med. Chem. 8:949.
- Heston, W.D. (1997) Urology 49:104.
Long Name
Alternate Names
Gene Symbol
UniProt
Additional PSMA/FOLH1/NAALADase I Products
Product Documents for Human PSMA/FOLH1/NAALADase I Antibody
Product Specific Notices for Human PSMA/FOLH1/NAALADase I Antibody
For research use only